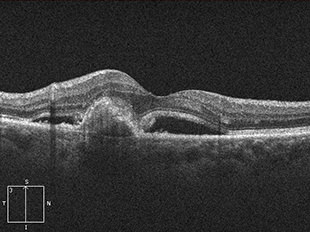
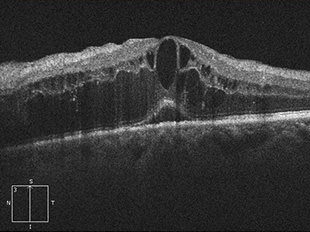
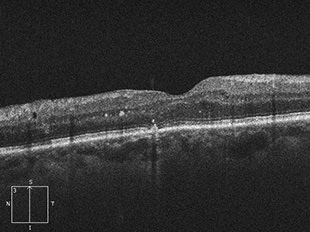
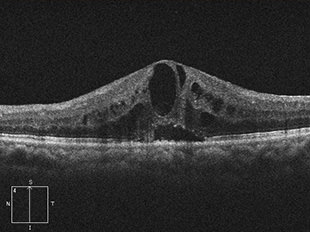
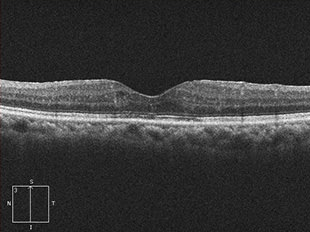
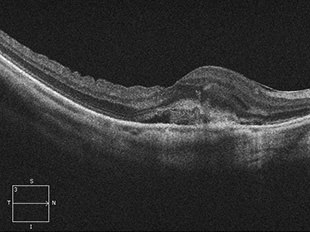
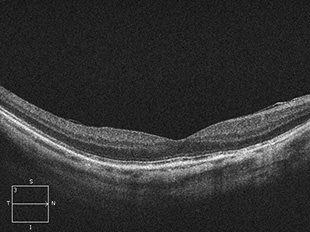

黄斑疾患
MACULAR DISEASE
- 診療のご案内
- 黄斑疾患
黄斑疾患について

抗VEGF薬治療(硝子体内注射)
視力低下の原因となる黄斑浮腫は網膜下におこる新生血管の増殖・成長や、網膜内の毛細血管から漏れ出す血液成分によって引き起こされます。そして、その原因となる物質がVEGF(血管内皮増殖因子)と言われています。
抗VEGF薬治療は、新生血管の成長を活発化させる体の中のVEGFという物質の働きを抑える薬です。眼の中(硝子体内)に注射することで、視力低下の原因となる新生血管の増殖や成長を抑えることが可能な治療法です。
現在この治療薬が用いられる疾患は、加齢黄斑変性、糖尿病黄斑浮腫、網膜静脈閉塞症、病的近視に伴う脈絡膜新生血管があります。
なお、疾患の状態によって複数回の注射が必要になったり、他の治療法を併用する場合もあります。
抗VEGF薬治療は、新生血管の成長を活発化させる体の中のVEGFという物質の働きを抑える薬です。眼の中(硝子体内)に注射することで、視力低下の原因となる新生血管の増殖や成長を抑えることが可能な治療法です。
現在この治療薬が用いられる疾患は、加齢黄斑変性、糖尿病黄斑浮腫、網膜静脈閉塞症、病的近視に伴う脈絡膜新生血管があります。
なお、疾患の状態によって複数回の注射が必要になったり、他の治療法を併用する場合もあります。
加齢黄斑変性
加齢黄斑変性とは、網膜のほぼ中心部分にあたる特に視機能において重要な部位である黄斑部に、年齢的な変化・変性が生じて起こる病気です。加齢と名のつく通り年配者に多く、近年患者数が急増しており、欧米では失明原因の上位にあげられています。
ものを見る上で特に重要な役割を担う黄斑に障害が起こるため、視野の中心が見えにくい、暗く見える、ものが歪んで見える等、視覚上に症状が出ます。また起こる視力低下の度合いはまちまちですが、矯正視力でも0.1以下という高度の視力障害が起きることもあります。
ものを見る上で特に重要な役割を担う黄斑に障害が起こるため、視野の中心が見えにくい、暗く見える、ものが歪んで見える等、視覚上に症状が出ます。また起こる視力低下の度合いはまちまちですが、矯正視力でも0.1以下という高度の視力障害が起きることもあります。

治療前

治療後
治療前 OCT

治療後 OCT
糖尿病黄斑浮腫
糖尿病黄斑浮腫は、糖尿病網膜症の合併症として発症します。網膜の細い血管に瘤ができてもろくなり、血管から血液中の成分がもれだし、それが網膜内にたまり浮腫(むくみ)を起こします。特に視機能において重要な部位である黄斑部に浮腫が生じると、ものが見えづらくなります。さらに浮腫が黄斑の中心部にまで及ぶと、著しい視力障害をきたし、かすんで見えたり、見えないところができたり、歪みが生じたりします。

治療前

治療後
治療前 OCT
治療後 OCT
※レーザー光凝固や硝子体手術を行う場合もあります。また、血糖コントロールも重要です。
網膜静脈閉塞症
網膜静脈閉塞症は、網膜の静脈が詰まった状態で発症します。網膜の静脈が詰まると静脈の圧力が上がり、網膜の血管が広がったり、蛇行したり、出血したりします。また、網膜に血液中の水分がたまり黄斑付近に発症すると黄斑浮腫を起こします。
詰まった静脈の場所により、網膜中心静脈閉塞症、網膜静脈分枝閉塞症などに分類されます。
網膜静脈閉塞症の患者さんの多くは、高血圧のある方です。これは、高血圧により、血管がダメージを受けること、つまり動脈硬化が影響しています。
高血圧のほかにも、血管自体の炎症により発症したり、糖尿病などの血液の粘性が増す病気がある方でも発症しやすくなります。また、緑内障のある方も発症しやすいと言われています。
網膜の静脈が詰まってしまうため、網膜に出血や浮腫が起こります。そのため、ものが見えにくくなる、見えない部分があるなどの症状が出ます。特に黄斑部分に出血や浮腫ができると、視力が急に下がったり、かすんだり、黒く見えたり、歪んで見えたりします。
詰まった静脈の場所により、網膜中心静脈閉塞症、網膜静脈分枝閉塞症などに分類されます。
網膜静脈閉塞症の患者さんの多くは、高血圧のある方です。これは、高血圧により、血管がダメージを受けること、つまり動脈硬化が影響しています。
高血圧のほかにも、血管自体の炎症により発症したり、糖尿病などの血液の粘性が増す病気がある方でも発症しやすくなります。また、緑内障のある方も発症しやすいと言われています。
網膜の静脈が詰まってしまうため、網膜に出血や浮腫が起こります。そのため、ものが見えにくくなる、見えない部分があるなどの症状が出ます。特に黄斑部分に出血や浮腫ができると、視力が急に下がったり、かすんだり、黒く見えたり、歪んで見えたりします。

治療前

治療後
治療前 OCT
治療後 OCT
※硝子体手術を行う場合もあります。
病的近視における脈絡膜新生血管
病的近視とは、近視のなかでも眼軸長(眼の前後の長さ)が伸びているため、さまざまな眼底の病気を伴うものをさします。
病的近視における脈絡膜新生血管は、病的近視の方の5~10%に起こる病気で、新生血管からの出血や、もれ出た血液成分(滲出液)があるため、見えない部分ができたり、ゆがみが生じたりします。
病的近視における脈絡膜新生血管は、病的近視の方の5~10%に起こる病気で、新生血管からの出血や、もれ出た血液成分(滲出液)があるため、見えない部分ができたり、ゆがみが生じたりします。

治療前

治療後
治療前 OCT
治療後 OCT
